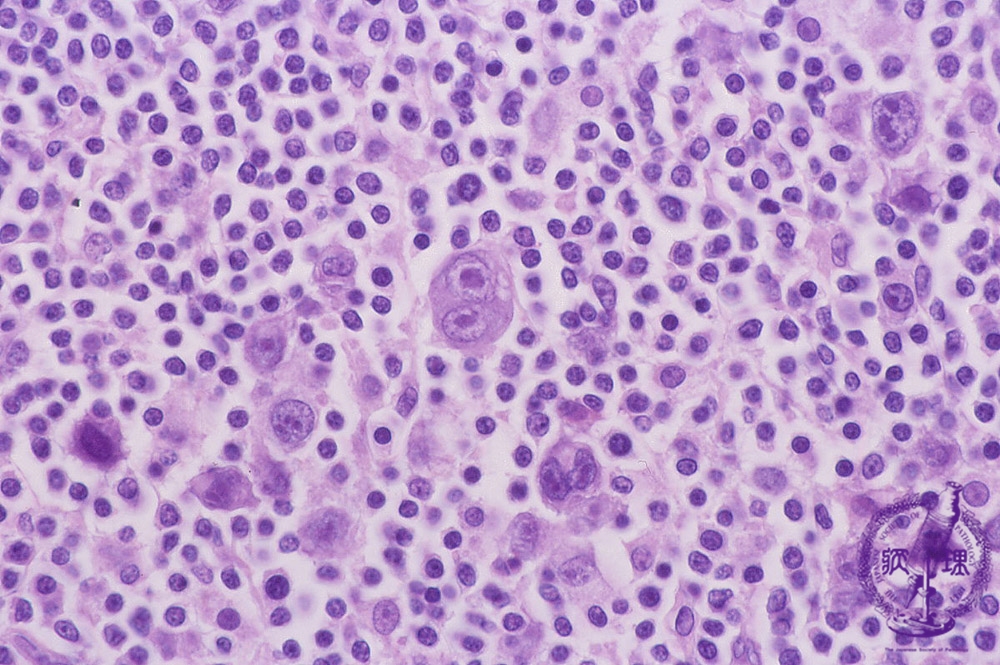
原因と危険因子

ホジキンリンパ腫と非ホジキンリンパ腫はどちらも白血球で始まります。ただし、通常、体のさまざまな領域で発生し、症状や見通しも異なります。
リンパ腫はリンパ系のがんです。ホジキンリンパ腫 (HL) は、非ホジキンリンパ腫 (NHL) ほど一般的ではありません。
この記事では、有病率、症状、見通し、原因、治療法などの主な違いを詳しく説明して、HL と NHL を比較します。
リンパ腫はリンパ系内で発生するがんです。リンパ系は、体全体の血管、リンパ節、管のネットワークです。それは免疫システムの重要な要素です。
HL と NHL はリンパ腫の 2 つの主要な形態であり、どちらも白血球で始まります。
HL
2022年の論文によると、HLには結節性リンパ球優位型HLと古典的HLという2つのサブタイプがある。 HL の約 95% はクラシックです。
科学者は古典的な HL をさらに次のカテゴリに分類します。
- 結節性硬化症
- リンパ球が豊富な
- 混合細胞性
- リンパ球が枯渇した
NHL
2022年の別の記事によると、科学者は影響を受けた細胞に従ってNHLを分類しています。 NHL は、異なる種類の白血球である T 細胞または B 細胞に影響を与えます。
NHL にはいくつかの形式があります。一般的な T 細胞 NHL には次のものがあります。
- 腸疾患関連 T 細胞リンパ腫
- 未分化大細胞リンパ腫
- 成人T細胞リンパ腫
一般的な B 細胞 NHL には次のものがあります。
専門家は、HL患者はリード・スタンバーグ細胞の量が多いと述べています。これらは、複数の核を含む異常な白血球です。これらの細胞は、NHL 患者にはほとんど存在しません。
リード・シュテルンバーグ細胞のレベルにおけるこの相違に加えて、HL と NHL の間には他の重要な違いがあります。
次の表は、HL と NHL のいくつかの違いをまとめたものです。
| ホジキンリンパ腫 | 非ホジキンリンパ腫 | |
|---|---|---|
| どれほど珍しいのでしょうか? | 人口10万人当たりの新規感染者数は約2.6人となっている。 | 人口10万人当たりの新規感染者数は約19人となっている。 |
| その見通しはどのようなものでしょうか? | 全体の5年相対生存率は89.1%です。 | 全体の5年相対生存率は73.8%です。 |
| 最初はどこで発達するのでしょうか? |
どこからでも始まりますが、最も一般的には次のような上半身のリンパ節で始まります。
• 首 • 胸 • 脇の下 |
リンパ組織が存在する体のどこからでも発症する可能性があります。 |
相対生存率は、特定の疾患のある人が診断を受けた後に、その疾患のない人と比較してどれくらい生存するかを知るのに役立ちます。
たとえば、5 年相対生存率が 70% の場合、この疾患のある人は、疾患のない人に比べて 5 年間生存する可能性が 70% 高くなります。
これらの数値は推定値であることを覚えておくことが重要です。自分の状態が自分にどのような影響を与えるかについて医療専門家に相談することができます。
このセクションでは、リンパ腫の有病率に関するその他の重要な事実について説明します。
HL
米国癌協会 (ACS) によると、2022 年に米国で新たに HL が発生した患者数は 8,540 人でした。
これらのがんは、若い成人、特に 20 代の人々に最も一般的です。通常、有病率は 20 代を過ぎると低下し、55 歳以降に再び上昇します。
監視・疫学・最終結果 (SEER) プログラムでは、年間 10 万人あたり 2.6 人の HL 症例が存在すると述べています。
NHL
ACS によると、2022 年に米国で新たに NHL が発生したのは 80,470 人でした。
あらゆる年齢の人に影響を与える可能性があります。しかし、NHL 患者の半数以上が 64 歳以降にこの症状を発症します。
SEERは、人口10万人当たり年間19人の新たなNHL症例が発生していると述べている。
HL と NHL にはいくつかの共通の症状があります。ただし、症状にはいくつかの重要な違いがあります。
HL
ACS が説明しているように、リンパ節の肥大は HL の最も一般的な症状です。これらは多くの場合、皮膚の下に隆起やしこりとして現れます。これは、首、鼠径部、または脇の下の領域の可能性があります。
HL のその他の症状には次のものがあります。
- 食欲不振
- かゆみ
- 倦怠感
HL 患者は「B 症状」を発症することもあります。これらには次のものが含まれます。
- 夜間に大量の発汗をする
- 感染症のない発熱、再発し続ける可能性がある
- 6か月以内に体重の少なくとも10%が減少する
これらの B 症状は、リンパ節の腫れほど一般的ではありません。
NHL
NHL 患者ではリンパ節の腫れも発生します。ただし、ACS には、NHL のその他の一般的な症状もリストされています。
NHL 患者は、上記の B 症状を発症する可能性もあります。
HL と NHL には見通しに大きな違いがあります。
HL
SEER は、HL の各段階に基づいて次の 5 年相対生存率を示しています。
| ステージ | 5年相対生存率 |
|---|---|
| ステージ1 | 92.4% |
| ステージ2 | 95% |
| ステージ3 | 86.4% |
| ステージ4 | 79.8% |
| 未知の段階 | 83.6% |
NHL
SEER は、NHL の各段階に基づいて次の 5 年相対生存率を示しています。
| ステージ | 5年相対生存率 |
|---|---|
| ステージ1 | 86.5% |
| ステージ2 | 78.1% |
| ステージ3 | 72.3% |
| ステージ4 | 63.9% |
| 未知の段階 | 69.1% |
以下に、HL および NHL の原因と危険因子のいくつかを概説します。
HL
HLは、白血球が異常に増殖し始めると発症します。
専門家には、なぜこのようなプロセスが起こるのかはわかっていません。ただし、ACS には HL のリスクを高めるいくつかの要因がリストされています。
これらには次のものが含まれます。
- エプスタイン・バーウイルス感染症に罹患したことがある
- 20~30歳、または55歳以上であること
- 免疫力が低下している
- 男性であること
親戚がHLに罹患している場合、個人もHLのリスクが高くなります。
NHL
科学者たちはNHLの原因を知りません。しかし、彼らはこの症状の幅広い危険因子を特定しました。
ACS はそれらを次のようにリストします。
- 年上であること
- 白人であること
- NHLの家族歴がある
- 放射線被ばくを経験したことがある
- 免疫力が低下している
- 自己免疫疾患を患っている
一部の感染症は NHL の危険因子でもあります。これらには次のものが含まれます。
- エプスタイン・バーウイルス
- ヒトT細胞リンパ指向性ウイルス感染症
- ヒトヘルペスウイルス8型感染症
HL と NHL の主な治療選択肢は部分的に重複しています。具体的な治療内容はケースバイケースで異なります。
HL
国立がん研究所 (NCI) が説明しているように、医師には HL を治療する方法がいくつかあります。治療方法には次のようなものがあります。
- 化学療法、幹細胞移植の有無にかかわらず
- 放射線治療
- 免疫療法
- 標的療法
治療法によっては、妊娠中の人には適さないものもあります。たとえば、多くの化学療法は胎児に有害となる可能性があります。
NHL
NCI は、NHL の主な治療法を列挙しています。
- 化学療法(幹細胞移植の有無にかかわらず)
- 放射線治療
- 免疫療法
- 標的療法
- 手術
- 抗生物質療法
- 血漿交換療法
医師は、症状の進行を観察するために治療を一時停止するなど、注意深く待つことを推奨する場合もあります。
HL と NHL は、リンパ系の 2 つの主要な種類の癌です。どちらも白血球から始まりますが、体の異なる領域で発生し、症状や見通しも異なります。
いずれかのタイプのリンパ腫の症状に気づいた場合は、医師に連絡する必要があります。
ホジキンリンパ腫と非ホジキンリンパ腫の違いは何ですか?・関連動画
参考文献一覧
- https://www.ncbi.nlm.nih.gov/books/NBK559328/
- https://www.cancer.org/cancer/hodgkin-lymphoma/about/what-is-hodgkin-disease.html
- http://www.medicalnewstoday.com/articles/323343
- https://www.cancer.org/cancer/non-hodgkin-lymphoma/detection-diagnosis-staging/signs-symptoms.html
- https://seer.cancer.gov/statfacts/html/nhl.html
- https://www.cancer.org/cancer/hodgkin-lymphoma/detection-diagnosis-staging/signs-and-symptoms.html
- https://www.cancer.org/cancer/non-hodgkin-lymphoma/about/key-statistics.html
- https://seer.cancer.gov/statfacts/html/hodg.html
- https://www.cancer.org/cancer/hodgkin-lymphoma/about/key-statistics.html
- https://www.cancer.org/cancer/non-hodgkin-lymphoma/about/what-is-non-hodgkin-lymphoma.html
- http://www.medicalnewstoday.com/articles/248002
- https://www.cancer.org/cancer/hodgkin-lymphoma/causes-risks-prevention/risk-factors.html
- https://www.cancer.org/cancer/non-hodgkin-lymphoma/causes-risks-prevention/risk-factors.html
- https://www.ncbi.nlm.nih.gov/books/NBK65804/
- https://www.ncbi.nlm.nih.gov/books/NBK65899/
- https://www.ncbi.nlm.nih.gov/books/NBK499969/